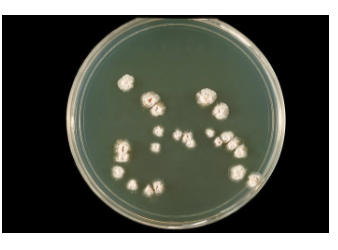

Bacillus, Clostridium, Listeria
Medically Important Gram- Positive Bacilli
can be subdivided into 3 general groups, based on presence or absence of endospores and acid-fastness
3 general groups:
endospore-formers: bacillus, clostridium
non-endospore-formers: listeria, erysipelothrix
irregular shaped and staining properties: actinomyces, nocardia, corynebacterium

Spore-Forming Bacilli
genus bacillus
genus clostridium
genus sporolactobacillus

General Characteristics of the Genus Bacillus
gram- positive, endospore-forming, motile rods
mostly saprobes, habitat: soil
obligate aerobic or facultative and catalase positive
versatile in degrading complex macromolecules
source of antibiotics
primary habitat is soil
2 species of medical importance:
bacillus anthracis

bacillus cereus
Bacillus Anthracis
virulence factors - capsule and 3 exotoxin combination
protective Ag- entry pore
edema factor - increase cAMP
lethal factor - cleave host MAPK
3 types of anthrax:
cutaneous- spores enter through skin, black sore- eschar; least dangerous

pulmonary- inhalation of spores

gastrointestinal- ingested spores

both pulmonary and GI- exotoxins lead to cardiovascular shock and death (40-45% mortality with current treatments)
Control and Treatment
diagnosis - use phage or DFA = direct fluorescent Ab
treated with pencillin, tetracycline, or ciprofloxacin
burn or decontaminate animal carcasses, gas sterilize imported materials
vaccines
live spores and toxoid to protect livestock
purified toxoid; for high risk occupations and military personnel; toxoid 6 inoculations over 1.5 years; annual boosters
Bacillus Cereus
common airborne and dustborne; usual methods of disinfection and antisepsis are ineffective; facultative
grows in foods, spores survive cooking and reheating
ingestion of heat stable enterotoxin-containing food causes nausea, vomiting, abdominal cramps, and diarrhea; 24-hour duration
heat labile enterotoxin, bacterial growth-diarrheal, lasts longer
no treatment
increasingly reported in immunosuppressed- severe pneumonia, wound infections
eye infections- rapid blindness, drug resistance
The Genus Clostridium
gram-positive, spore-forming rods
anaerobic and catalase negative- spores produced only under anaerobic conditions
120 species
oval or spherical spores produced only under anaerobic conditions
synthesize organic acids, alcohols, and exotoxins
cause wound infections, tissue infections, and food intoxications
Gas Gangrene
clostridium perfringens most frequent clostridia involved in soft tissue and wound infections
spores found in soil, human skin, intestine, and vagina
predisposing factors - surgical incisions, compound fractures, diabetic ulcers, septic abortions, puncture wounds, gunshot wounds
soft tissue/ wound infections
gas gangrene- 2 forms
anaerobic cellulitis - localized to damaged area
myonecrosis - toxins cause damage to spread
damaged /dead tissue + anaerobic conditions - germination, vegetative growth and release f toxins, fermentation of muscle carbohydrates - formation of gas and further destruction of tissue
25% mortality; if treatment delayed, or septicemia near 100%
gas gangrene diagnostic for clostridial wound infection
Virulence Factors
factors
alpha toxin - causes RBC rupture, edema, and tissue destruction
collagenase
hyaluronidase
DNase

Treatment and Prevention
immediate cleansing of dirty wounds, deep wounds, compound fractures, and infected incisions
debridement of disease tissue
large doses of cephalosoporin or penicillin; protein synthesis inhibitors- inhibit toxin production
hyperbaric oxygen therapy
no vaccines available
Tetanus
clostridium tetani
common resident of soil and GI tracts of animals
causes tetanus or lockjaw, a neuromuscular disease
most commonly among geratric patients and IV drug abusers; neonates in developing countries
Pathology
spores usually enter through accidental puncture wounds, burns, umbilical stumps, frostbite, and crushed body parts
anaerobic environment is required for vegetative cells to grow and release toxin

tetanospasmin - neurotoxin causes paralysis by binding to motor nerve endings; blocking the release of neurotransmitter for muscular contraction inhibition; muscles contract uncontrollably
death most often due to paralysis of respiratory muscles

Neonatal Tetanus

Treatment and Prevention
treatment aimed at deterring degree of toxemia and infection and maintaining homeostasis
antitoxin therapy with human tetanus immune globulin; antibodies inactivates circulating toxin but not counteract that which is already bound
metronidazole drug of choice (efficient penetration into wounds and abcesses); and muscle relaxants
tetanus toxoid vaccine available; booster needed every 10 years
Clostridium difficile- associated disease (CDAD)
normal resident of colon, in low numbers
causes antibiotic-associated colitis
relatively non-invasive; treatment with broad-spectrum antibiotics kills the other bacteria, allowing C. difficile to overgrow
produces enterotoxins that damage intestines
major cause of diarrhea in hospitals
increasingly common in community-acquired diarrhea
ELISA of stool for diagnosis
Treatment and Prevention
mild uncomplicated cases respond to fluid and electrolyte replacement and withdrawal of antimicrobials
severe infections treated with oral vancomycin or metronidazole and replacement cultures
increased precautions to prevent spread

mild uncomplicated cases respond to fluid and electrolyte replacement nd withdrawal of antimicrobials
severe infections treated with oral vancomycin or metronidazole and replacement cultures
increased precautions to prevent spread
Clostridial Food Poisoning
clostridium botulinum - rare but severe intoxication usually from home canned food
clostridium perfringens - mild intestinal illness; second most common form of food poisoning worldwide
Botulinum Food Poisoning
botulism - intoxication associated with inadequate food preservation
clostridium botulinum - spore-forming anaerobe; commonly inhabitats soil and water
Pathogenesis
spores are present on soil, water, food when gathered and processed
if reliable temperature and pressure are not achieved (anaerobic) air will be evacuated but spores will remain
anaerobic conditions favor spore germination and vegetative growth
potent toxin, botulin, is released

botulin toxin is carried to neuromuscular junctions and blocks the release of acetylcholine, necessary for muscle contraction to occur
double or blurred vision, difficulty swallowing, neuromuscular symptoms
Infant and Wound Botulism
infant botulism - caused by ingested spores that germinate and release toxin; flaccid paralysis
wound botulism - spores enter wound, germinate, release toxin and cause food poisoning symptoms

Treatment and Prevention
determine presence of toxin in food, intestinal contents or feces
administer antitoxin; cardiac and respiratory support
infectious botulism treated with penicillin
practice proper methods of preserving and handling canned foods; addition of preservatives
Clostridium Gastroenteritis
clostrium perfringens
spores contaminate food that has not been cooked thoroughly enough to destroy spores
spores germinate and multiply (especially if unrefrigerated)
when consumed, exotoxin is produced in the intestine; acts on epithelial cells, acute abdominal pain, diarrhea, and nausea
rapid recovery
Spore-Forming Pathogens

Gram- Positive Regular Non-Spore-Forming Bacilli
regular: stain uniformly and do not assume pleomorphic shapes
medically important:
Listeria monocytogenes
Erysipelothrix rhusiopathiae
Listeria monocytogenes
non-spore forming gram-positive
ranging from coccobacilli to long filaments
1-4 flagella and lack capsules
resistant to cold, heat, salt, pH extremes, and bile
virulence attributed to ability to replicate in the cytoplasm of cells after inducing phagocytosis; low pH triggers listeriolysin O; creates pore ion phagosome; bacteria released in cytosol; avoids humoral immune system

Epidemiology and Pathology
primary reservoir in soil and water; animal intestines
can contaminate foods and grow during refrigeration
listeriosis- most cases associated with dairy products, poultry, and meat
often mild or subclinical in normal adults; dangerous for pregnant women
immunocompromised patients, fetuses, and neonates; affects brain and meninges
20% death rate
Diagnosis and Control
culture requires lengthy cold enrichment process
rapid diagnostic tests using ELISA, immunofluorescence, and DNA analysis
ampicillin and trimethoprim/sulfamethoxazole
prevention - pasteurization and cooking
Erysipelothrix rhusiopathiae
gram - positive rod widely distributed in animals and the environment
primary reservoir - tonsils of healthy pigs
enters through skin abrasion, multiplies to produce erysipeloid, dark red lesions, fever, joint pain, rarely septicemia
penicillin or erythromycin and vaccine for pigs

Gram- Positive Irregular Non-Spore-Forming Bacilli
irregular: pleomorphic, stain unevenly
medically important genera:
Corynebacterium
Propionibacterium
Mycobacterium
Actinomyces
Nocardia
Filamentous Bacilli
Genera Actinomyces & Nocardia nonmotile filamentous bacteria
Actinomyces
many normal flora, opportunistic, non motile
role in plaque and dental caries
Actinomycoses - chronic infection of skin and soft tissues - associated oral care
rarely associated with > 4 yrs non-copper IUDs

Nocardia
soil organisms
N. brasiliensis - pulmonary like TB and brain abscesses
N. asteroids - mycetoma, slow destructive infection of tissue and bone

Corynebacterium diptheriae
gram-positive irregular bacilli, pleomorphic, catalase positive

Epidemiology
reservoir of healthy carriers; potential for diphtheria is always present
most cases occur in non-immunized children living in crowded, unsanitary conditions
acquired via respiratory droplets from carriers or actively infected individuals
sporadic in adults - immunity wanes

Pathology
2 stages of disease:
local infection - upper respiratory tract inflammation (primary infection)
sore throat, nausea, vomiting, swollen lymph nodes;
pseudomembrane
formation can cause asphyxiation
cutaneous (secondary infection)
diptherotoxin production and toxemia
target organs - primarily heart and nerves; death rate: 5-10%; from bacteriophage

Diphtherotoxin

cleavage of leader during secretion
B-bind heparin- binding EGF (high surface heart and liver cells) translocate A domain
A- inactivate EF-2 (1/ribosome)
Diagnostic Methods
gray pseudomembrane and swelling indicative
stain, serology - culture
slow, biochemistry required
Elek test - antitoxin binding

Treatment and Prevention
antitoxin
penicillin or erythromycin
prevented by toxoid vaccine series and boosters